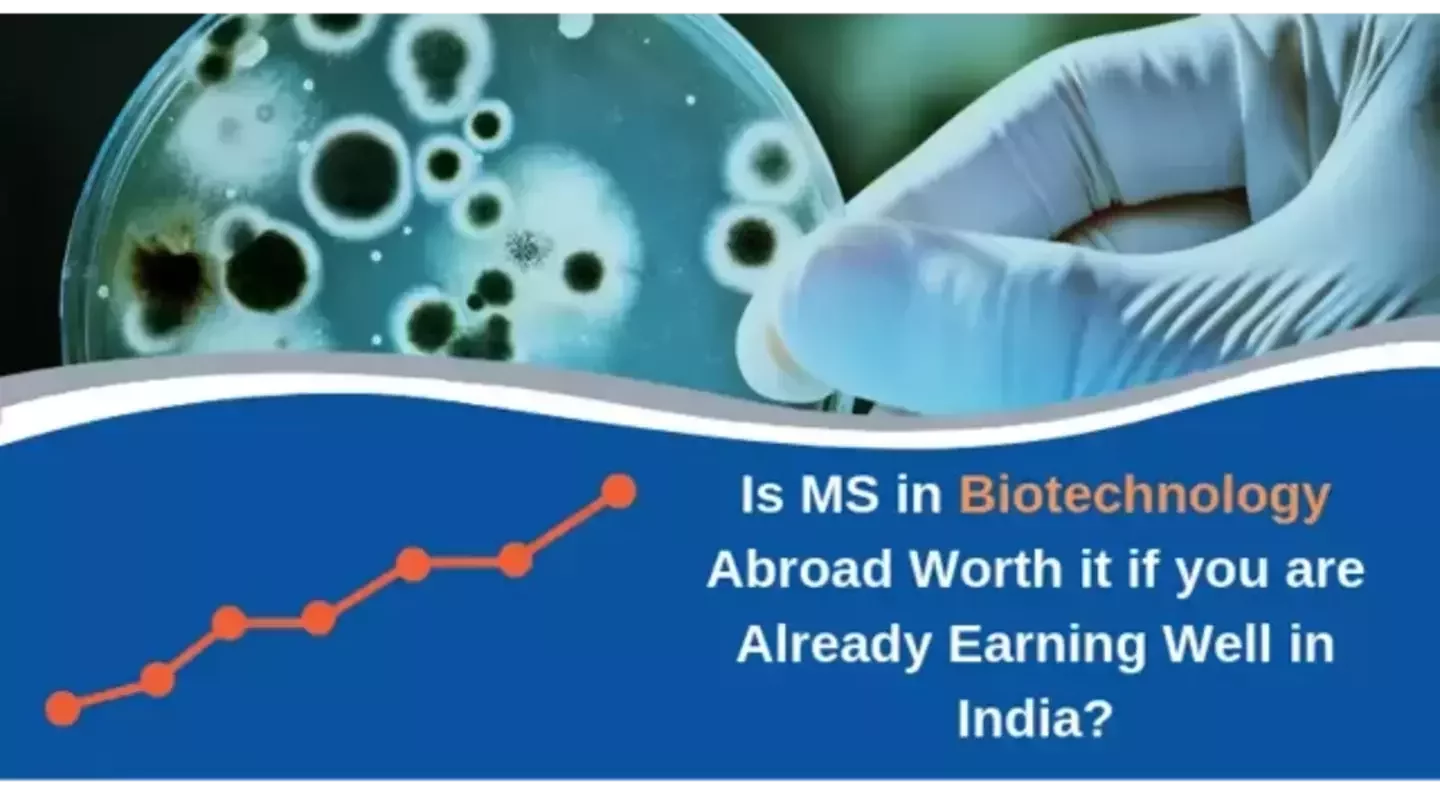
Is MS in Biotechnology  Abroad Worth it if you are Already Earning Well in India

Get instant loan offer suitable to your profile !

On this Page:
Is choosing MS in Biotechnology abroad over your current job in India a financially sound move? Using our Estimate Earning Tools, we calculate the risks and returns involved in the investment.
In this article under our “Is it Worth Studying MS Abroad if you are Already Earning Well in India,” we will be assessing the financial worth of doing MS in Biotechnology abroad. We have already covered five MS courses, Mechanical Engineering, Chemical Engineering, Computer Science, Aerospace Engineering and Material Science, in our series which you can check by clicking on the given links. However, if your desired course is MS in Biotechnology, stick around!
Check Your Education Loan Eligibility

The global biotechnology market is expected to reach $727.1 billion by 2025 with a growth rate of 7.4%.
So if you wish to make hay while the sun shines, it might be the right time to consider doing a Master’s in Biotechnology course from a top university in the US, Canada, Europe or Australia. It could prove to be the key to a thriving career ahead, especially given the fact that most of the top biotech companies are headquartered in the US or Europe. Canada ranks higher while Australia stands almost at par with India in terms of the biotech industry revenues.
Struggling with Your Admissions?

In spite of the ample scope of Biotechnology in foreign countries, taking the decision to pursue MS abroad is easier said than done. There are a number of factors that need to be considered before taking the leap forward. Although job prospects and opportunities for growth do factor in while assessing the worth of pursuing higher education abroad, it is the financial expenses and the expected amount of returns which are usually the most decisive factors. Would the investment in doing MS abroad give handsome returns? Would the benefits after MS in Biotechnology abroad be worth the hard work and risk of leaving a job in India and giving up on the current salary ? These are some of the questions that determine the decision to do an MS abroad.
We suggest that to take a financially sound decision, one must consider the estimate earnings the investment would bring one. It is for this very purpose, we bring to you a country-wise analysis of the estimate earnings and savings after doing MS in Biotechnology abroad depending upon the current salary you are drawing in India. We have arrived at these outcomes using our Future Earnings Tool. You could use the tool on your own as well to check the results as per your exact current salary.
Before we proceed, please note that the tool takes into account a few assumptions while calculating the future estimate earnings which you should read here before proceeding with the breakup so that you have an informed idea. Also, throughout this analysis, we will be using certain terms the definitions of which we have stated below for your clearer understanding.
 NPV (Net Present Value): It is the discounted difference between the present values of cash inflows and outflows over a fixed period of time. The higher the NPV, the better the investment.
NPV (Net Present Value): It is the discounted difference between the present values of cash inflows and outflows over a fixed period of time. The higher the NPV, the better the investment.
 IRR (Internal Rate of Return): It gives the idea of an investment’s rate of return. The higher the IRR, the smarter it is to invest.
IRR (Internal Rate of Return): It gives the idea of an investment’s rate of return. The higher the IRR, the smarter it is to invest.
 Profit: It is the money that one is expected to save while studying and working abroad.
Profit: It is the money that one is expected to save while studying and working abroad.
For our analyses, we have taken colleges falling between the ranks 1 and 500 for each country and grouped them into distinct rank brackets. For each salary group earned in India, we then analyze the NPV, IRR and Profit for each rank group to assess whether it is worth doing MS in Biotechnology from a certain country. Readers may note that all the figures in the tables below are computed for 10 years from the start of the loan repayment period considering that the loan will be repaid in 5 years.

If you are earning ₹ 5 lakhs per annum in India:
|
1-50 |
1.18 Crores |
67% |
2.2 Crores |
|
51-100 |
1 Crore |
62% |
1.96 Crores |
|
101-250 |
79 Lakhs |
52% |
1.53 Crores |
|
251-500 |
81 Lakhs |
58% |
1.54 Crores |
Verdict: Since the NPV is very encouraging, leaving a job in India that earns you ₹ 5 lakhs a year and opting for MS in Biotechnology from the US would be a great investment.
If you are earning ₹ 15 lakhs per annum in India:
|
1-50 |
13.4 Lakhs |
14% |
49.6 Lakhs |
|
51-100 |
(-) 1 Lakh |
8% |
24.7 Lakhs |
|
101-250 |
(-) 26 Lakhs |
(-) 7% |
(-) 18 Lakhs |
|
251-500 |
(-) 24 Lakhs |
(-) 8% |
(-) 17.9 Lakhs |
Verdict: There is no harm in doing MS in Biotechnology from a top 50 university for the discipline from the US if you are earning ₹ 15 lakhs per annum in India. But for the same salary, if you are not able to make it to a top 50 university, it would not be a smart decision. As the Net present value is negative.
If you are earning ₹ 25 lakhs per annum in India:
|
1-50 |
(-) 90 Lakhs |
Negative |
(-) 1.2 Crores |
|
51-100 |
(-) 1.04 Crore |
Negative |
(-) 1.45 Crores |
|
101-250 |
(-) 1.3 Crores |
Negative |
(-) 1.88 Crores |
|
251-500 |
(-) 1.27 Crores |
Negative |
(-) 1.87 Crores |
Verdict: The NPV is significantly negative regardless of college ranking. It would not be beneficial to do an MS in Biotechnology from the US if you are already making ₹ 25 lakhs annually in India.
If you are earning ₹ 5 lakhs per annum in India:
|
1-50 |
59 Lakhs |
43% |
1.2 Crores |
|
51-100 |
78 Lakhs |
79% |
1.41 Crores |
|
101-250 |
58 Lakhs |
64% |
1 Crore |
|
251-500 |
50 Lakhs |
57% |
96 Lakhs |
Verdict: You do not need to think twice if you are considering doing MS in Biotechnology from Canada if your current salary is ₹ 5 lakhs per year in India. The NPV figures after doing MS in Canada are encouraging at this salary level.
If you are earning ₹ 15 lakhs per annum in India:
|
1-50 |
(-) 46 Lakhs |
(-) 30% |
(-) 54 Lakhs |
|
51-100 |
(-) 27 Lakhs |
Negative |
(-) 30 Lakhs |
|
101-250 |
(-) 47 Lakhs |
Negative |
(-) 64.5 Lakhs |
|
251-500 |
(-) 54.5 Lakhs |
Negative |
(-) 76.4 Lakhs |
Verdict: The NPV is remarkably negative regardless of college ranking. It would be better to not go for MS in Biotechnology from Canada if you are earning ₹ 15 lakhs per annum working in India.
If you are earning ₹ 25 lakhs per annum in India:
|
1-50 |
(-) 1.5 Crores |
Negative |
(-) 2.23 Crores |
|
51-100 |
(-) 1.3 Crores |
Negative |
(-) 2 Crores |
|
101-250 |
(-) 1.5 Crores |
Negative |
(-) 2.34 Crores |
|
251-500 |
(-) 1.58 Crores |
Negative |
(-) 2.46 Crores |
Verdict: The NPV figures are awfully negative for colleges of all rankings. We see no reason that you should go to Canada for MS in Biotechnology if you are already earning ₹ 25 lakhs a year in India.
If you are earning a salary of ₹ 5 lakhs per annum in India:
|
1-50 |
95.6 Lakhs |
112% |
1.68 Crores |
|
51-100 |
87.2 Lakhs |
112% |
1.53 Crores |
|
101-250 |
69.2 Lakhs |
99% |
1.22 Crores |
|
251-500 |
62 Lakhs |
88% |
1.1 Crores |
Verdict: The NPV figures are promising for colleges of all rankings. It would be a good decision to do MS in Biotechnology from Germany if your current salary is ₹ 5 lakhs/year in India. Try to make it to a top 100 college for Biotechnology to maximize the return on investment.
If you are earning ₹ 15 lakhs per annum in India:
|
1-50 |
(-) 9.5 Lakhs |
(-) 3% |
(-) 3.9 Lakhs |
|
51-100 |
(-) 18 Lakhs |
Negative |
(-) 19 Lakhs |
|
101-250 |
(-) 36 Lakhs |
Negative |
(-) 50 Lakhs |
Check Your Education Loan Eligibility

Ask from a community of 10K+ peers, alumni and experts
Trending Blogs
Similar Blogs

Network with a community of curious students, just like you
Join our community to make connections, find answers and future roommates.. Join our CommunityCountry-Wise Loans
Best Lenders for Education Loan

ICICI Bank

Axis Bank

Union Bank

Prodigy

Auxilo

Credila

IDFC

InCred

MPower

Avanse

SBI

BOB

Poonawalla

Saraswat